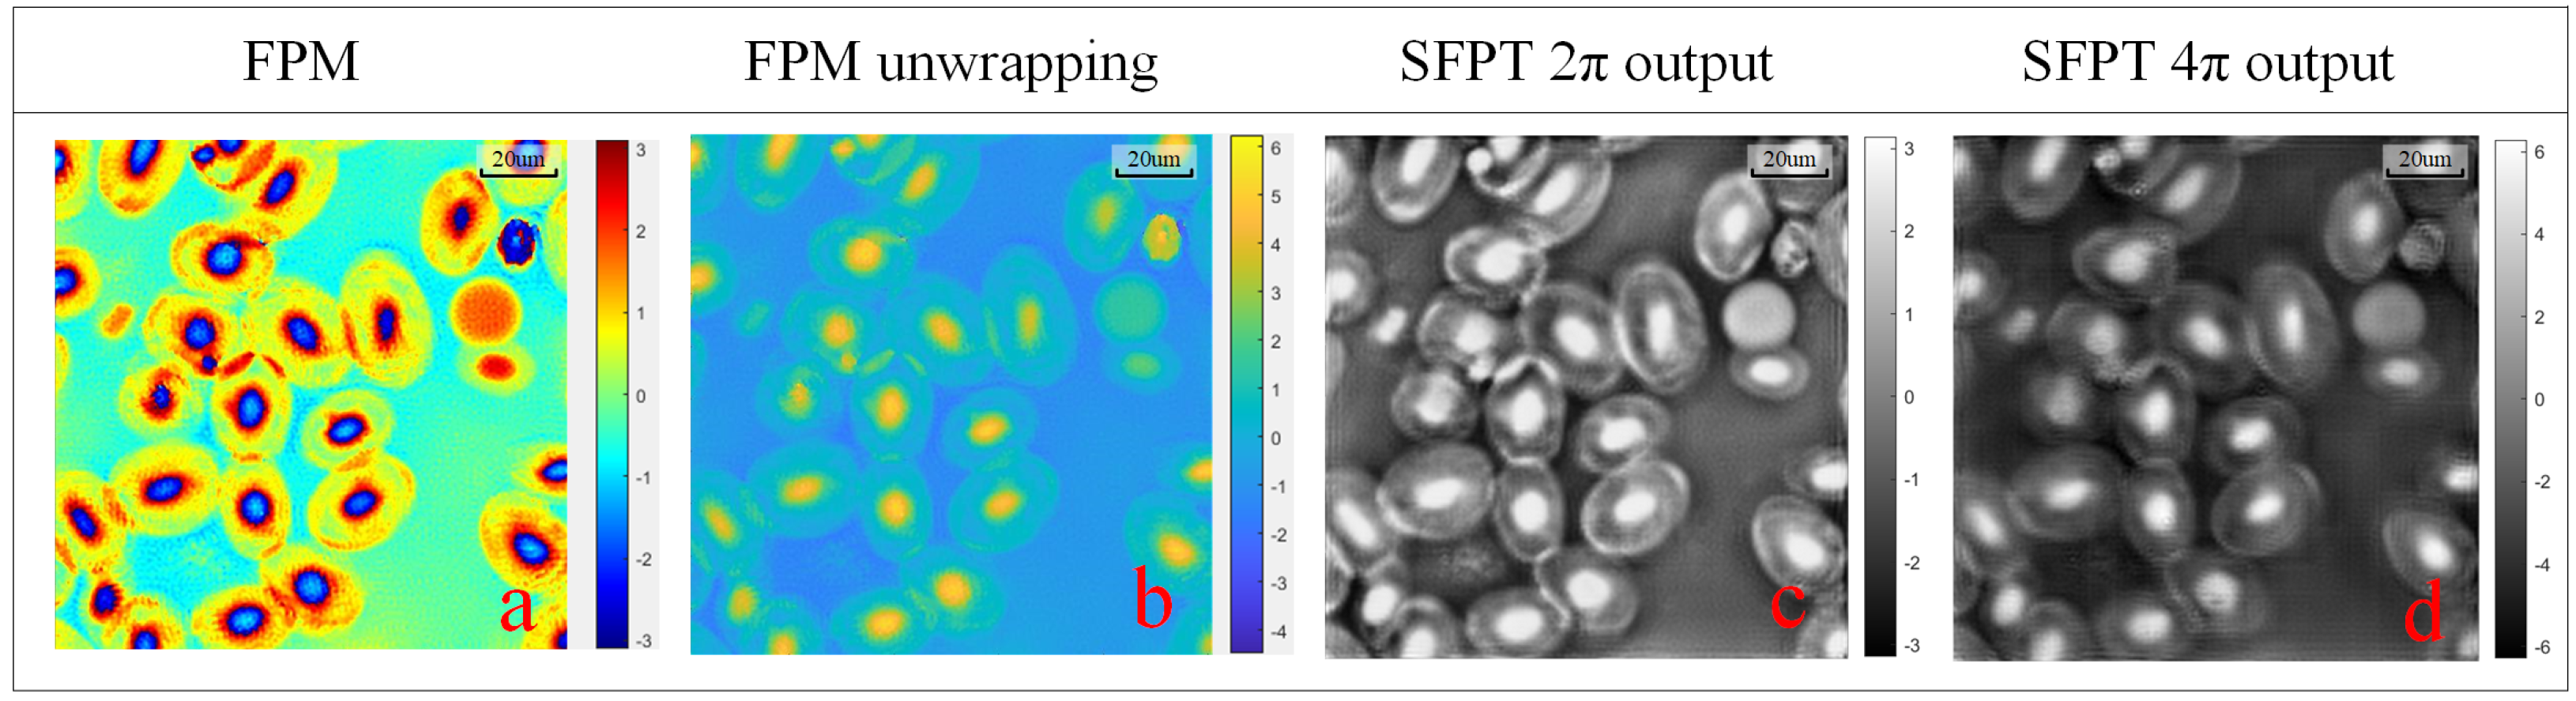
Applsci 15 00423 g008

Fourier Ptychographic Microscopy with Optical Aberration Correction and Phase Unwrapping Based on Semi-Supervised Learning
Abstract
1. Introduction
2. Principle of FPM
3. Semi-Supervised Fourier Ptychographic Transformer Network
4. Fourier Ptychographic Transformer Backbone Network
Loss Function
5. Experiments
5.1. Training Details
5.2. Experimental System and Model Parameters
5.3. Reconstruction Results
5.3.1. Simulated Dataset Reconstruction
5.3.2. Real Experiment Dataset Reconstruction
5.4. Phase Unwrapping
5.5. Ablation Experiment
6. Conclusions
Author Contributions
Funding
Institutional Review Board Statement
Informed Consent Statement
Data Availability Statement
Conflicts of Interest
References
- Zheng, G.; Horstmeyer, R.; Yang, C. Wide-field, high-resolution Fourier ptychographic microscopy. Nat. Photonics 2013, 7, 739–745. [Google Scholar] [CrossRef] [PubMed]
- Zheng, G.; Shen, C.; Jiang, S.; Song, P.; Yang, C. Concept, implementations and applications of Fourier ptychography. Nat. Rev. Phys. 2021, 3, 207–223. [Google Scholar] [CrossRef]
- Ou, X.; Horstmeyer, R.; Yang, C.; Zheng, G. Quantitative phase imaging via Fourier ptychographic microscopy. Opt. Lett. 2013, 38, 4845–4848. [Google Scholar] [CrossRef] [PubMed]
- Pan, A.; Zuo, C.; Yao, B. High-resolution and large field-of-view Fourier ptychographic microscopy and its applications in biomedicine. Rep. Prog. Phys. 2020, 83, 096101. [Google Scholar] [CrossRef]
- Xu, F.; Wu, Z.; Tan, C.; Liao, Y.; Wang, Z.; Chen, K.; Pan, A. Fourier Ptychographic Microscopy 10 Years on: A Review. Cells 2024, 13, 324. [Google Scholar] [CrossRef]
- Tian, L.; Liu, Z.; Yeh, L.H.; Chen, M.; Zhong, J.; Waller, L. Computational illumination for high-speed in vitro Fourier ptychographic microscopy. Optica 2015, 2, 904–911. [Google Scholar] [CrossRef]
- Zhang, Y.; Jiang, W.; Tian, L.; Waller, L.; Dai, Q. Self-learning based Fourier ptychographic microscopy. Opt. Express 2015, 23, 18471–18486. [Google Scholar] [CrossRef]
- Sun, J.; Zuo, C.; Zhang, L.; Chen, Q. Resolution-enhanced Fourier ptychographic microscopy based on high-numerical-aperture illuminations. Sci. Rep. 2017, 7, 1187. [Google Scholar] [CrossRef]
- Sun, J.; Zuo, C.; Zhang, J.; Fan, Y.; Chen, Q. High-speed Fourier ptychographic microscopy based on programmable annular illuminations. Sci. Rep. 2018, 8, 7669. [Google Scholar] [CrossRef]
- Bian, L.; Suo, J.; Zheng, G.; Guo, K.; Chen, F.; Dai, Q. Fourier ptychographic reconstruction using Wirtinger flow optimization. Opt. Express 2015, 23, 4856–4866. [Google Scholar] [CrossRef]
- Pan, A.; Zhang, Y.; Zhao, T.; Wang, Z.; Dan, D.; Lei, M.; Yao, B. System calibration method for Fourier ptychographic microscopy. J. Biomed. Opt. 2017, 22, 096005. [Google Scholar] [CrossRef] [PubMed]
- Nguyen, T.; Xue, Y.; Li, Y.; Tian, L.; Nehmetallah, G. Deep learning approach for Fourier ptychography microscopy. Opt. Express 2018, 26, 26470–26484. [Google Scholar] [CrossRef] [PubMed]
- Konda, P.C.; Loetgering, L.; Zhou, K.C.; Xu, S.; Harvey, A.R.; Horstmeyer, R. Fourier ptychography: Current applications and future promises. Opt. Express 2020, 28, 9603–9630. [Google Scholar] [CrossRef] [PubMed]
- Bouchama, L.; Dorizzi, B.; Thellier, M.; Klossa, J.; Gottesman, Y. Fourier ptychographic microscopy image enhancement with bi-modal deep learning. Biomed. Opt. Express 2023, 14, 3172–3189. [Google Scholar] [CrossRef]
- Wang, X.; Piao, Y.; Jin, Y.; Li, J.; Lin, Z.; Cui, J.; Xu, T. Fourier Ptychographic Reconstruction Method of Self-Training Physical Model. Appl. Sci. 2023, 13, 3590. [Google Scholar] [CrossRef]
- Wang, Y.; Guan, N.; Li, J.; Wang, X. A Virtual Staining Method Based on Self-Supervised GAN for Fourier Ptychographic Microscopy Colorful Imaging. Appl. Sci. 2024, 14, 1662. [Google Scholar] [CrossRef]
- Lu, X.; Wang, M.; Wu, H.; Hui, F. Deep learning for fast image reconstruction of Fourier ptychographic microscopy with expanded frequency spectrum. In Proceedings of the 4th Optics Young Scientist Summit (OYSS 2020), Ningbo, China, 4–7 December 2020; SPIE: Pune, India, 2021; Volume 11781, pp. 146–152. [Google Scholar]
- Kappeler, A.; Ghosh, S.; Holloway, J.; Cossairt, O.; Katsaggelos, A. Ptychnet: CNN based Fourier ptychography. In Proceedings of the 2017 IEEE International Conference on Image Processing (ICIP), Beijing, China, 17–20 September 2017; IEEE: Piscataway, NJ, USA, 2017; pp. 1712–1716. [Google Scholar]
- Zhang, J.; Xu, T.; Shen, Z.; Qiao, Y.; Zhang, Y. Fourier ptychographic microscopy reconstruction with multiscale deep residual network. Opt. Express 2019, 27, 8612–8625. [Google Scholar] [CrossRef]
- Bardozzo, F.; Fiore, P.; Valentino, M.; Bianco, V.; Memmolo, P.; Miccio, L.; Brancato, V.; Smaldone, G.; Gambacorta, M.; Salvatore, M.; et al. Enhanced tissue slide imaging in the complex domain via cross-explainable GAN for Fourier ptychographic microscopy. Comput. Biol. Med. 2024, 179, 108861. [Google Scholar] [CrossRef]
- Feng, T.; Wang, A.; Wang, Z.; Liao, Y.; Pan, A. Linear-space-variant model for Fourier ptychographic microscopy. Opt. Lett. 2024, 49, 2617–2620. [Google Scholar] [CrossRef]
- Wu, K.; Pan, A.; Sun, Z.; Shi, Y.; Gao, W. Blind deep-learning based preprocessing method for Fourier ptychographic microscopy. Opt. Laser Technol. 2024, 169, 110140. [Google Scholar] [CrossRef]
- Chen, Q.; Huang, D.; Chen, R. Fourier ptychographic microscopy with untrained deep neural network priors. Opt. Express 2022, 30, 39597–39612. [Google Scholar] [CrossRef] [PubMed]
- Jiang, S.; Guo, K.; Liao, J.; Zheng, G. Solving Fourier ptychographic imaging problems via neural network modeling and TensorFlow. Biomed. Opt. Express 2018, 9, 3306–3319. [Google Scholar] [CrossRef] [PubMed]
- Zhang, J.; Xu, T.; Li, J.; Zhang, Y.; Jiang, S.; Chen, Y.; Zhang, J. Physics-based learning with channel attention for Fourier ptychographic microscopy. J. Biophotonics 2022, 15, e202100296. [Google Scholar] [CrossRef] [PubMed]
- Zhang, J.; Tao, X.; Yang, L.; Wang, C.; Tao, C.; Hu, J.; Wu, R.; Zheng, Z. The integration of neural network and physical reconstruction model for Fourier ptychographic microscopy. Opt. Commun. 2022, 504, 127470. [Google Scholar] [CrossRef]
- Wang, Y.; Wang, Y.; Li, J.; Wang, X. Fourier Ptychographic Microscopy Reconstruction Method Based on Residual Local Mixture Network. Sensors 2024, 24, 4099. [Google Scholar] [CrossRef]
- Wu, K.; Pan, A.; Gao, W. Fourier ptychographic reconstruction with denoising diffusion probabilistic models. Opt. Laser Technol. 2024, 176, 111016. [Google Scholar] [CrossRef]
- Herráez, M.A.; Burton, D.R.; Lalor, M.J.; Gdeisat, M.A. Fast two-dimensional phase-unwrapping algorithm based on sorting by reliability following a noncontinuous path. Appl. Opt. 2002, 41, 7437–7444. [Google Scholar] [CrossRef]
- Ghiglia, D.C.; Romero, L.A. Robust two-dimensional weighted and unweighted phase unwrapping that uses fast transforms and iterative methods. JOSA A 1994, 11, 107–117. [Google Scholar] [CrossRef]
- Wang, L.; Liang, W.; Guo, W.; Wang, Z.; Wang, C.; Gao, Q. Multi task deep learning phase unwrapping method based on semantic segmentation. J. Opt. 2024, 26, 115709. [Google Scholar] [CrossRef]
- Zhao, L.; Zhou, X.; Lu, X.; Tong, H.; Fang, H. Transformer-based reconstruction for Fourier ptychographic microscopy. IEEE Access 2023, 11, 94536–94544. [Google Scholar] [CrossRef]
- Zhu, X.J. Semi-Aupervised Learning Literature Survey. University of Wisconsin-Madison. 2008. Available online: https://pages.cs.wisc.edu/~jerryzhu/pub/ssl_survey.pdf (accessed on 9 December 2024).
- Ou, X.; Zheng, G.; Yang, C. Embedded pupil function recovery for Fourier ptychographic microscopy. Opt. Express 2014, 22, 4960–4972. [Google Scholar] [CrossRef] [PubMed]
- Vaswani, A.; Shazeer, N.; Parmar, N.; Uszkoreit, J.; Jones, L.; Gomez, A.N.; Kaiser, Ł.; Polosukhin, I. Attention is all you need. In Proceedings of the 31st International Conference on Neural Information Processing Systems, Long Beach, CA, USA, 4–9 December 2017; pp. 6000–6010. [Google Scholar]
- Ouyang, E.; Li, B.; Hu, W.; Zhang, G.; Zhao, L.; Wu, J. When Multigranularity Meets Spatial–Spectral Attention: A Hybrid Transformer for Hyperspectral Image Classification. IEEE Trans. Geosci. Remote. Sens. 2023, 61, 1–18. [Google Scholar] [CrossRef]
- Liu, Z.; Lin, Y.; Cao, Y.; Hu, H.; Wei, Y.; Zhang, Z.; Lin, S.; Guo, B. Swin transformer: Hierarchical vision transformer using shifted windows. In Proceedings of the IEEE/CVF International Conference on Computer Vision, Virtual Conference, 10 March 2021; pp. 10012–10022. [Google Scholar]
- Wang, Z.; Bovik, A.C.; Sheikh, H.R.; Simoncelli, E.P. Image quality assessment: From error visibility to structural similarity. IEEE Trans. Image Process. 2004, 13, 600–612. [Google Scholar] [CrossRef] [PubMed]
- Agustsson, E.; Timofte, R. Ntire 2017 challenge on single image super-resolution: Dataset and study. In Proceedings of the 2017 IEEE Conference on Computer Vision and Pattern Recognition Workshops (CVPRW), Honolulu, HI, USA, 21–26 July 2017; pp. 126–135. [Google Scholar]
- Coppo, J.A.; Mussart, N.B.; Fioranelli, S.A. Blood and urine physiological values in farm-cultured Rana catesbeiana (Anura: Ranidae) in Argentina. Rev. Biol. Trop. 2005, 53, 545–559. [Google Scholar] [CrossRef] [PubMed]

| Supervised Learning | Zernike Modes | Pixel and Channel Self-Attention | Amplitude PSNR/SSIM | Phase PSNR/SSIM |
|---|---|---|---|---|
| × | × | × | 17.97/0.2317 | 14.94/0.3168 |
| × | × | √ | 18.021/0.2326 | 15.74/0.3175 |
| × | √ | × | 27.16/0.8540 | 18.51/0.9014 |
| √ | × | × | 18.29/0.2261 | 15.00/0.2493 |
| √ | √ | × | 26.37/0.8595 | 21.07/0.9080 |
| √ | √ | √ | 26.53/0.8591 | 21.67/0.9176 |
Disclaimer/Publisher’s Note: The statements, opinions and data contained in all publications are solely those of the individual author(s) and contributor(s) and not of MDPI and/or the editor(s). MDPI and/or the editor(s) disclaim responsibility for any injury to people or property resulting from any ideas, methods, instructions or products referred to in the content. |
© 2025 by the authors. Licensee MDPI, Basel, Switzerland. This article is an open access article distributed under the terms and conditions of the Creative Commons Attribution (CC BY) license (https://creativecommons.org/licenses/by/4.0/).
Share and Cite
Zhou, X.; Tong, H.; Ouyang, E.; Zhao, L.; Fang, H. Fourier Ptychographic Microscopy with Optical Aberration Correction and Phase Unwrapping Based on Semi-Supervised Learning. Appl. Sci. 2025, 15, 423. https://doi.org/10.3390/app15010423
Zhou X, Tong H, Ouyang E, Zhao L, Fang H. Fourier Ptychographic Microscopy with Optical Aberration Correction and Phase Unwrapping Based on Semi-Supervised Learning. Applied Sciences. 2025; 15(1):423. https://doi.org/10.3390/app15010423
Chicago/Turabian StyleZhou, Xuhui, Haiping Tong, Er Ouyang, Lin Zhao, and Hui Fang. 2025. "Fourier Ptychographic Microscopy with Optical Aberration Correction and Phase Unwrapping Based on Semi-Supervised Learning" Applied Sciences 15, no. 1: 423. https://doi.org/10.3390/app15010423
APA StyleZhou, X., Tong, H., Ouyang, E., Zhao, L., & Fang, H. (2025). Fourier Ptychographic Microscopy with Optical Aberration Correction and Phase Unwrapping Based on Semi-Supervised Learning. Applied Sciences, 15(1), 423. https://doi.org/10.3390/app15010423

